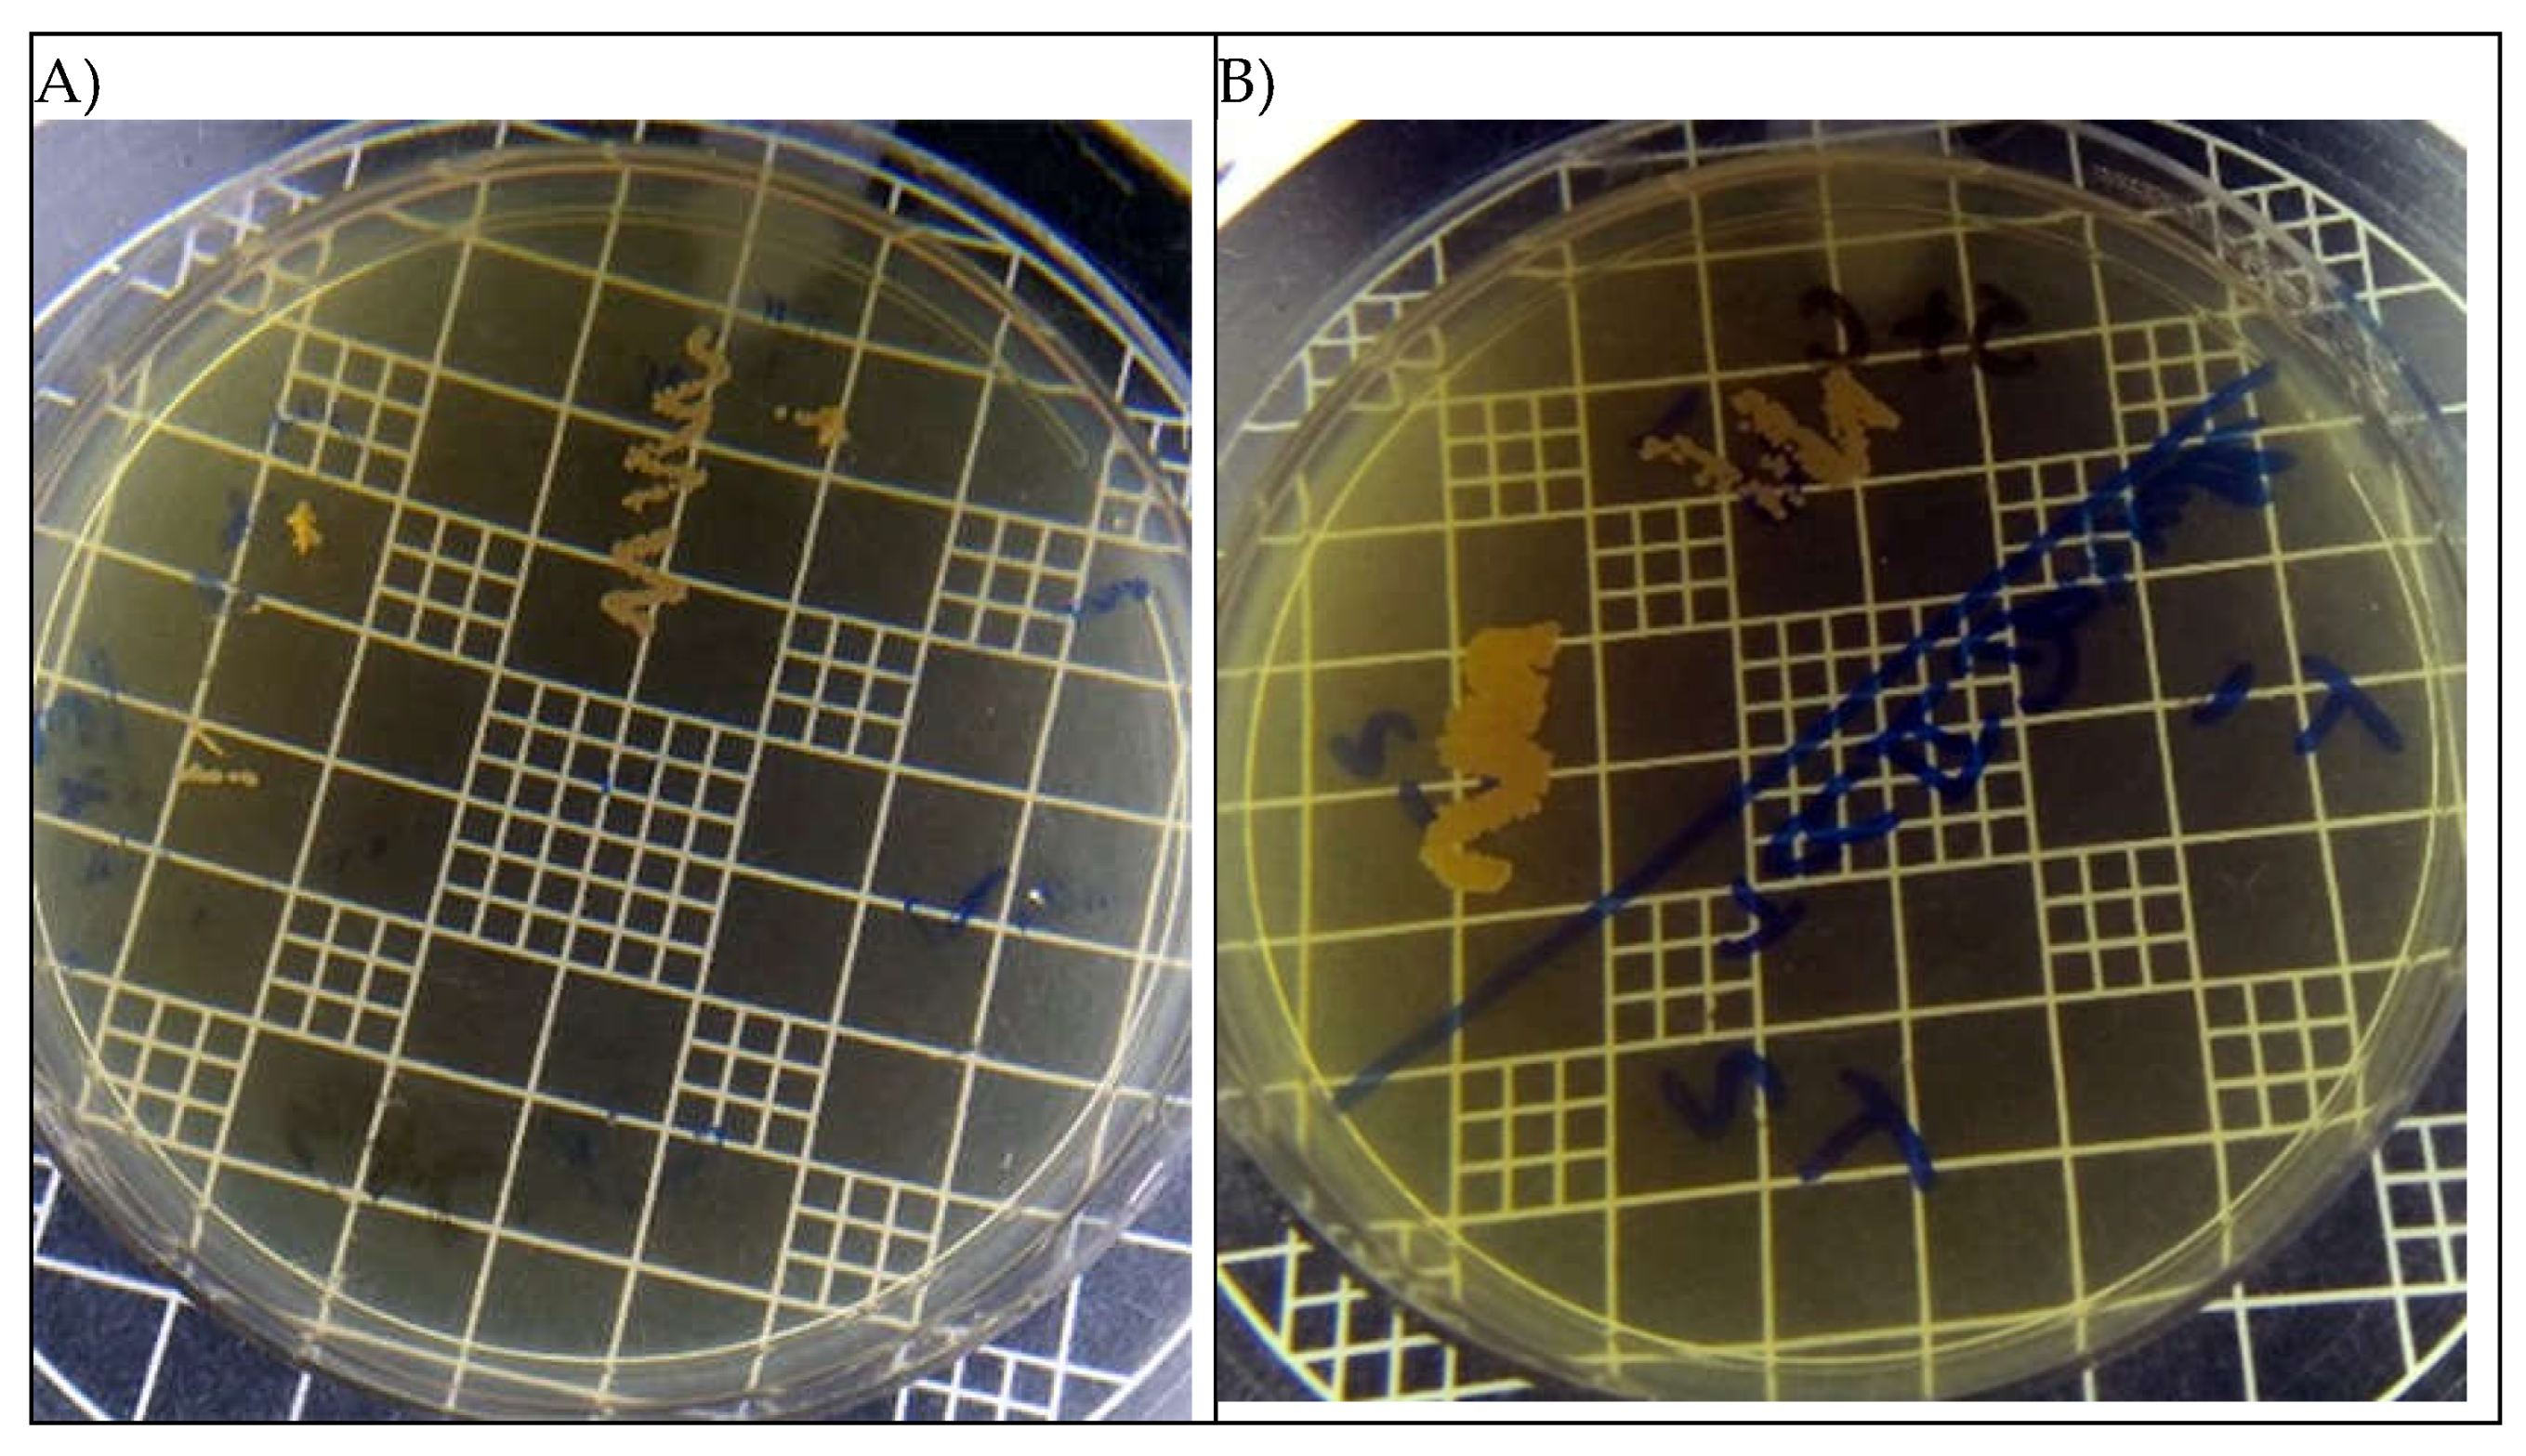
Preprints 118062 g003

1. Introduction
The speed that microorganisms acquire resistance, both to the immune system and to commercial drugs, is increasing [
1].
Candida albicans stands out among them as a species that belongs to the human microbiota [
2], but which is also capable of promoving invasive infections, leading to blood and systemic contagions after tissue rupture [
3].
This species has a vast resistance to known antifungals drugs due to its strong virulence factors, emphasizing the secretion of hydrolytic enzymes and adhesins, phenotypic switching, dimorphisms and rapid adaptation to temperature [
4] and being capable of associating with biofilms [
5].
Genetic factors also strongly contribute to the proliferation of this microorganism. The ALS gene family stands out for being directly linked to the polymorphism of biofilms [
6]. Meanwhile the expression of HWP1, ALS1, ALS3 genes is associated with the adhesion of this fungus [
7].
Some studies demonstrate that natural products obtained from plants can interact with the genetic material of some microorganisms and lead to antimicrobial effects. Isolated from clove, the eugenol compound has been described for showing antifungal activity [
8].
This is a phenolic and volatile substance known for its antimicrobial activity [
9]. It is found among family Myrtaceae species [
10] and it is native to the Moluccas, Indonesia [
11].
Studies show that the compound has multiple applications, from a rapid anesthetic induction of Nile tilapia [
12] to antibacterial [
13], used as antiseptic mouthwash [
14], antioxidant [
15] and antiparasitic [
16].
Eugenol has also been described as a potential antifungal agent that acts directly on the pathogen's plasma membrane, changing the pH and causing cell inactivation through H+ATPase, a dominant protein that performs most of the physiological functions of the pathogen and it’s essential in maintaining the electrolyte balance of the fungus [
17].
In addition, it can also act directly on fungal transporters, especially in the active sites of two amino acid permeases, Tat1p and Gap1p, located in the cytoplasmic membrane of yeasts, modifying its permeability, causing changes in its compliance and leading to cellular extravasation [
18].
Activities against Candida sp. showed that it was able to modify the morphogenesis of the yeast cell envelope, interfering with enzymes that catalyze polysaccharides, harming cell wall development [
19].
In this sense, the objective of this report was to evaluate the antifungal activity of eugenol against the Candida albicans genomic DNA.
2. Materials and Methods
2.1. Research
This is an experimental quantitative research whose activities were performed at the Molecular Biology Laboratory of the Leão Sampaio University Center (UNILEÃO), Juazeiro do Norte – CE, from September to November 2019.
2.2. Microorganisms
The strain Candida albicans INCQS 40006 was used for this test. To obtain a fungal sample, 1mL of fungal culture in a Sabouraud dextrose liquid medium with chloramphenicol was placed in separate 1.5mL tubes.
2.3. Obtaining the Test Solution
For antifungal activity tests, the compound was used in its pure concentration (100%) and also prepared in four concentrations: 12.5%, 25%, 50% and 75%. To prepare these solutions, the compound was dissolved in Dimethylsulfoxide (DMSO) and diluted in sterile water. Control samples were performed using only DMSO to avoid any possible interferences in the interpretation that could affect the results.
2.4. Extraction of Fungal Genomic DNA
1 - The microorganism was collected and added to a microtube containing 500µL of cell lysis buffer (0.15M NaCl; 50M Tris – HCl; 10mM EDTA; 2% SDS; pH 8) and it was incubated at 65°C for one hour.
2 - 500µL of phenol/chloroform (1:1) were added in the microtube and vortexed for 15 minutes. Then it was centrifuged for 15 minutes at 13000rpm and the aqueous suspension was removed and added to a new microtube.
3 - 400µL of phenol was added in this suspension containing DNA, vortexed for 5 minutes and centrifuged for 15 minutes at 13000rpm. The aqueous suspension was exposed to another extraction method with 400µl of phenol.
4 - 1mL of pure ethanol was added to the supernatant and this microtube was stored for 1 hour at -20°C. After a 15-minute centrifugation at 13000rpm, the pellet was washed with ice-cold 70% ethanol, dried at room temperature and resuspended by adding 80µL of DNase-free ultrapure water on the microtube.
5 - The material was treated with 3µl of RNAse (Invitrogen, Carlsbad, CA) at a concentration of 50µg/mL for 30 minutes at 37ºC.
6 - The quality of the DNA was visually verified under UV light using 0.8% agarose gel electrophoresis and stained using 0.5µg/mL of Blue Green Loading Dye. The microtubes containing the DNA were stored at -20ºC [
20].
7 - After obtaining the DNA samples, each concentration of the eugenol compound was placed in contact with this sample for about 24 hours to verify if there was any kind of interaction with the fungal DNA. As a control, a DNA sample without eugenol was used and the DNA ladder pattern was used to compare the concentrations.
2.5. Preparation of Agarose Gel and Electrophoresis
Analysis in agarose gel electrophoresis: The preparation of the agarose gel and the electrophoresis procedure followed the criteria presented by Borda et al. [
21].
2.6. Microbiological Tests
For the confirmatory cell death test, the fungal strains were grown in Brain Heart Infusion (BHI), incubated at 37°C for 24 hours. The inoculum concentration was standardized according to the McFarland scale to adjust the turbidity of bacterial suspensions by comparing inoculum turbidity using a value of 0.5 on the scale. 100uL of eugenol was added to one of the two inoculums and the other one remained only with the medium, being used as a positive control for fungal growth. The inoculums were used for plating on Sabouraud Dextrose Agar (SDA – KASVI), to confirm if there was cell death at a concentration of 100mL of Eugenol, the test was performed in duplicate.
After the first plating, Candida albicans was washed with TE buffer solution (Tris - EDTA) to remove the eugenol and inoculated again in BHI medium, for another 24 hours at 37°C, to evaluate its recovery capacity.
3. Results
As shown in
Figure 1, it is possible to observe the DNA of Candida albicans after a period of 50 minutes in agarose gel, on the sides there are two types of DNA ladder, which emission of light seen under UV light allows estimating (in nanograms per microliter) the amount of DNA present in that band.
The positive control is shown in the upper part, with 9ug/uL of DNA. In sequence there are concentrations of 12.5%, 25%, 50%, 75% and 100% eugenol. In test 1, Eugenol was evaluated in different concentrations, as shown in
Figure 1, in concentrations equal to or bigger than 75% of the substance, the pathogen had no replicative activity.
Figure 1.
Fungal DNA applied to the agarose gel containing the inoculum in direct contact with different concentrations of eugenol. M= 1 Kb Plus DNA ladder (Fisher Scientific International Inc); 1=Positive Control; 2= 12,5% Eugenol; 3= 25% Eugenol; 4= 50% Eugenol; 5= 75% Eugenol; 6= 100% Eugenol.
Figure 1.
Fungal DNA applied to the agarose gel containing the inoculum in direct contact with different concentrations of eugenol. M= 1 Kb Plus DNA ladder (Fisher Scientific International Inc); 1=Positive Control; 2= 12,5% Eugenol; 3= 25% Eugenol; 4= 50% Eugenol; 5= 75% Eugenol; 6= 100% Eugenol.
In test 2, the ability of the fungus to recover after the effect of eugenol was evaluated. After test 1, the DNA was washed with TE buffer solution to remove the substance and then placed in 1mL of BHI and incubated again for 24 hours at 36 – 37°C.
Figure 2 shows different contractions of genomic DNA observed through under UV light, where the positive control is located on the upper left side as strongly positive band, followed by concentrations 12.5%, 25%, 50%, 75% and 100 % eugenol, showing that at the biggest concentration, no DNA was obtained.
In the confirmatory tests of cell death, for test 1, which evaluates different concentrations of eugenol in direct contact with the inoculum, it can be observed in
Figure 3, there was no fungal growth on agar confirming what was seen in electrophoresis, where at a concentration of 100% the substance was fungistatic, showing that eugenol has the ability to interrupt the progression of fungal growth.
For test 2, performed in duplicate, the inoculums were centrifuged, and the yeast cells were settled to the bottom of the eppendorf where they were washed with TE buffer solution to remove eugenol, as it shows in
Figure 3B, Candida albicans was not able to recover what can demonstrate that 100% eugenol is fungicidal and its pure concentration killed completely this pathogen, with no ability to recover.
4. Discussion
Eugenol concentrations equal to or less than 50%, showed a reduction in its growth, but not enough to completely inhibit its proliferation. The presence of fungal DNA is observed in concentrations equal to or less than 50%, since Candida albicans has different genetic mechanisms that are still unclear, but it contributes to make this species resistant. Its rapid adaptation to the environment is directly proportional to its transcription program, making it more stable [
22].
Several microbiological studies carried out with eugenol show its ability to inhibit the growth of
Candida albicans [
23] and these results are consistent with the present research which observed that in agarose gel at concentrations equal to or bigger than 75% there was no DNA left, demonstrating that there was an interruption in fungal development.
Eugenol performs an anti-candida effect by promoting serious damage to its envelope and modifying its morphogenesis and cell development [
24]. The same result was observed for other authors, demonstrating that eugenol has anticandida activity, but in contrast they believe that the destruction of the pathogen is not associated with its cell wall, but the inactivation of ergosterol synthesis and increase in the production of free radicals [
25].
It is noteworthy that, when tested against 100% eugenol, this fungus was unable to recover, even after being given adequate nutrients and temperature for its development. The performance of eugenol in adherent cells and consequently in the biofilm formed by Candida albicans depends directly on its concentration, which was observed in the results of the present study [
26].
Eugenol acts against the development of biofilms, when added before fungal cultivation, it acts before it is formed, and when added after biofilm formation, this substance was able to interrupt its progression, through electromicrography, they observed the reception of the cell membranes of the sessile cells (cells with low levels of sterol), still being reported its synergism with fluconazole (antimycotic drug) [
27].
Phenolic compounds have antifungal action through non-competitive enzymatic inhibition, interrupting the production of mycotoxins, such as aflatoxin (toxin present in food) that is capable of causing damage to human health and lipid peroxidases by blocking oxidative stress through the non-formation of peroxides, thus hindering their biosynthesis [
28].
In infections caused by
Candida sp, the most used methodology is the cultivation in different medium, but this leads to a delay in acquiring the results and it can easily suffer interference from the environment, such as contamination, for example, due to the waiting time. Therefore, science has evolved towards faster methods with lower risks of contamination, such as PCR or qPCR, which is real-time PCR with quantitative and qualitative results that can be obtained within three hours [
29].
5. Conclusions
Through the results, the analyzes demonstrated that Eugenol has fungostatic and fungicidal effects on the DNA of Candida albicans in different concentrations, emphasizes the 100% Eugenol concentration that had a fungicidal action, making the fungus unable to recover even after removing the substance and giving this microorganism good conditions for its proliferation.
At lower concentrations, only a delay in fungal proliferation was observed, it can be due several resistance mechanisms produced by Candida albicans, whether to drug substances, herbal medicines or the immune system. Thus, this research presents to the scientific community more information about the antifungal potential of Eugenol, and further studies are needed so this might be considered as a commercial drug for the treatment of Candida albicans infections.
Author Contributions
D.G.S. and D.L.S.J. wrote the manuscript and compiled the data; F.A.S. and T.T.A.Y. carried out the microbiological and molecular biology experiments; M.K.N.S.L. coordinated the project and carried out tests; I.R.A.M. and H.D.M.C. took part in revising and finalizing the manuscript.
Institutional Review Board Statement
Not applicable.
Informed Consent Statement
Not applicable.
Data Availability Statement
The data will be available after a reasonable request to the corresponding authors.
Conflicts of Interest
The authors declare no conflicts of interest.
References
- Menezes, T.O.A.; Alves, A.C.B.A.; Vieira, J.M.S.; Menezes, S.A.F.; Alves, B.P.; Mendonça, L.C.V. Avaliação in vitro da atividade antifúngica de óleos essenciais e extratos de plantas da região amazônica sobre cepa de Candida albicans. Rev. Odontol. UNESP 2009, 38(3), 184-91. Available in: https://revodontolunesp.com.br/article/588018907f8c9d0a098b4ce2.
- Levinson, W. Microbiologia médica e imunologia, 13rd ed.; Publisher: AMGH, Porto Alegre, Brazil, 2016.
- Gow, N.A.; Yadav, B. Microbe Profile: Candida albicans: a shape-changing, opportunistic pathogenic fungus of humans. Microbiology 2017, 163(8), 1145-1147. [CrossRef]
- Khan, M.S.A.; Ahmad, I.; Aqil, F.; Owais, M.; Shahid, M.; Musarrat, J. (2010). Virulence and pathogenicity of fungal pathogens with special reference to Candida albicans. In Ahmad, I., Owais, M., Shahid, M., Aqil, F. (eds) Combating Fungal Infections. Springer, Berlin, Heidelberg Combating fungal infections: Problems and remedy, Springer, Berlin, Heidelberg, 2010, pp. 21-45. [CrossRef]
- Sardi, J.C.O.; Scorzoni, L.; Bernardi, T.; Fusco-Almeida, A.M.; Giannini, M.J.S.M. Candida species: current epidemiology, pathogenicity, biofilm formation, natural antifungal products and new therapeutic options. J. Med. Microbial. 2013, 62(1), 10-24. [CrossRef]
- OLIVEIRA, M.M.M.; Brugnera, D.F.; Piccoli, R.H. Biofilmes microbianos na indústria de alimentos: uma revisão. RIAL 2010, 69(3), 277-284. Available in: https://periodicoshomolog.saude.sp.gov.br/index.php/RIAL/article/view/32626.
- Nailis, H.; Kucharíková, S.; Řičicová, M.; Van Dijck, P.; Deforce, D.; Nelis, H.; Coenye, T. Real-time PCR expression profiling of genes encoding potential virulence factors in Candida albicans biofilms: identification of model-dependent and-independent gene expression. BMC microbial. 2010, 10, 1-11. [CrossRef]
- Bennis, S.; Chami, F.; Chami, N.; Bouchikhi, T.; Remmal, A. Surface alteration of Saccharomyces cerevisiae induced by thymol and eugenol. Lett. Appl. Microbiol. 2004, 38(6), 454-458. [CrossRef]
- Affonso, R.S.; Rennó, M.N.; Slana, G.B.; Franca, T.C. Aspectos químicos e biológicos do óleo essencial de cravo da índia. RVQ 2012, 4(2), 146-161. [CrossRef]
- Bachiega, T.F.; Sousa, J.P.B.; Bastos, J.K.; Sforcin, J.M. Clove and eugenol in noncytotoxic concentrations exert immunomodulatory/anti-inflammatory action on cytokine production by murine macrophages. J. Pharm. Pharmacol. 2012, 64(4), 610-616. [CrossRef]
- Silvestri, J.D.F.; Paroul, N.; Czyewski, E.; Lerin, L.; Rotava, I.; Cansian, R.L.; Mossi, A.; Toniazzo, G.; Oliveira, D.; Treichel, H. Perfil da composição química e atividades antibacteriana e antioxidante do óleo essencial do cravo-da-índia (Eugenia caryophyllata Thunb.). Rev. Ceres (Impr.) 2010, 57, 589-594. [CrossRef]
- Vidal, L.V.O.; Albinati, R.C.B.; Albinati, A.C.L.; Lira, A.D.D.; Almeida, T.R.D.; Santos, G.B. Eugenol como anestésico para a tilápia-do-nilo. Pesqui. Agropec. Bras. 2008, 43, 1069-1074. [CrossRef]
- Beraldo, C.; Daneluzzi, N.S.; Scanavacca, J.; Doyama, J.T.; Fernandes Júnior, A.; Moritz, C.M.F. Eficiência de óleos essenciais de canela e cravo-da-índia como sanitizantes na indústria de alimentos. PAT 2013, 43, 436-440. [CrossRef]
- Mazzafera, P. Efeito alelopático do extrato alcoólico do cravo-da-índia e eugenol. Braz. J. Bot. 2003, 26, 231-238. [CrossRef]
- Morais, S.M.D.; Cavalcanti, E.S.; Costa, S.M.O.; Aguiar, L.A. Ação antioxidante de chás e condimentos de grande consumo no Brasil. Rev. Bras. Farmacogn. 2009, 19, 315-320. [CrossRef]
- Ueda-Nakamura, T.; Mendonça-Filho, R.R.; Morgado-Díaz, J.A.; Maza, P.K.; Dias Filho, B.P.; Cortez, D.A.G.; Alviano, D.S.; Rosa, M.S.S.; Lopes, A.H.C.S.; Alviano, C.S.; Nakamura, C.V. Antileishmanial activity of Eugenol-rich essential oil from Ocimum gratissimum. Parasitol. Int. 2006, 55(2), 99-105. [CrossRef]
- Ahmad, A.; Khan, A.; Yousuf, S.; Khan, L.A.; Manzoor, N. Proton translocating ATPase mediated fungicidal activity of eugenol and thymol. Fitoterapia 2010, 81(8), 1157-1162. [CrossRef]
- Darvishi, E.; Omidi, M.; Bushehri, A.A.S.; Golshani, A.; Smith, M. L. The antifungal eugenol perturbs dual aromatic and branched-chain amino acid permeases in the cytoplasmic membrane of yeast. PloS one 2013, 8(10), e76028. [CrossRef]
- Braga, P. C.; Dal Sasso, M.; Culici, M.; Alfieri, M. Eugenol and thymol, alone or in combination, induce morphological alterations in the envelope of Candida albicans. Fitoterapia 2007, 78(6), 396-400. [CrossRef]
- Alves, I.A.; Camargo, F.P.D.; Goulart, L.S. Identificação por PCR e sensibilidade a antifúngicos de isolados clínicos vaginais de Candida sp. Rev. Soc. Bras. Med. Trop. 2010, 43, 575-579. [CrossRef]
- Borda, C.C.; Petecofa, R.; Tejadaa, E.C.S.; Vega, C.; Costa, C. Análise da eficiência do gel de agar-agar na eletroforese de DNA. Atas de Ciências da Saúde 2015, 3(3). Available in: https://revistaseletronicas.fmu.br/index.php/ACIS/article/view/1064.
- Hube, B. From commensal to pathogen: stage-and tissue-specific gene expression of Candida albicans. Curr. Opin. Microbiol. 2004, 7(4), 336-341. [CrossRef]
- Schmidt, E.; Jirovetz, L.; Wlcek, K.; Buchbauer, G.; Gochev, V.; Girova, T.; Stoyanova, A.; Geissler, M. Antifungal activity of eugenol and various eugenol-containing essential oils against 38 clinical isolates of Candida albicans. JEOBP 2007, 10(5), 421-429. [CrossRef]
- Khan, S.N.; Khan, S.; Misba, L.; Sharief, M.; Hashmi, A.; Khan, A.U. Synergistic fungicidal activity with low doses of eugenol and amphotericin B against Candida albicans. Biochem. Biophys. Res. Commun. 2019, 518(3), 459-464. [CrossRef]
- Silva, I.C.G.; Santos, H.B.P.; Cavalcanti, Y.W.; Nonaka, C.F.W.; Sousa, S.A.; Castro, R.D. Antifungal activity of eugenol and its association with nystatin on Candida albicans. Pesqui. Bras. Odontopediatria Clin. Integr. 2017, 17(1), 1-8. Available in: https://www.redalyc.org/articulo.oa?id=63749543017.
- He, M.; Du, M.; Fan, M.; Bian, Z. In vitro activity of eugenol against Candida albicans biofilms. Mycopathologia 2007, 163, 137-143. [CrossRef]
- Khan, M.S.A.; Ahmad, I. Antibiofilm activity of certain phytocompounds and their synergy with fluconazole against Candida albicans biofilms. J. Antimicrob. Chemother. 2012, 67(3), 618-621. [CrossRef]
- Oliveira, M.D.S.; Dors, G.C.; Soares, L.A.D.S.; Furlong, E.B. Atividade antioxidante e antifúngica de extratos vegetais. Alim. Nutr. Araraquara 2007, 18(3), 267-275. Avaliable in: https://web.archive.org/web/20180421064540id_/http://serv-bib.fcfar.unesp.br/seer/index.php/alimentos/article/viewFile/163/171.
- Koehler, A.; Dallemole, D.R.; Riça, L.B.; Corbellini, V.A.; Rieger, A. Identificação de três espécies de Candida por PCR em tempo real. Rev. Jovens Pesqui. 2016, 6(1), 58-73. [CrossRef]
|
Disclaimer/Publisher’s Note: The statements, opinions and data contained in all publications are solely those of the individual author(s) and contributor(s) and not of MDPI and/or the editor(s). MDPI and/or the editor(s) disclaim responsibility for any injury to people or property resulting from any ideas, methods, instructions or products referred to in the content. |
© 2024 by the authors. Licensee MDPI, Basel, Switzerland. This article is an open access article distributed under the terms and conditions of the Creative Commons Attribution (CC BY) license (http://creativecommons.org/licenses/by/4.0/).